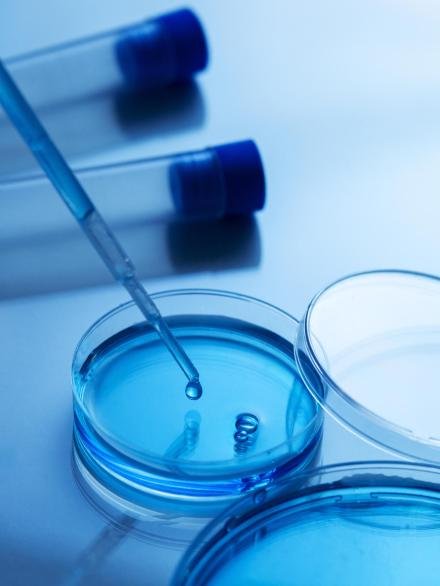

German Precision. Global Purpose.
GerMedCA is a Germany-based healthcare auditing, consulting and certification firm dedicated to transforming hospitals in developing countries.
Headquartered in Karlsruhe, Germany, with liaison offices in key developing regions, we collaborate closely with hospitals, healthcare teams, and regional stakeholders to raise care quality, modernize operations, and empower medical teams with international best practices
Ready to Raise Your Hospital’s Standards?
Our facilities
Emergency care
Consectetur adipiscing elit.
Modern laboratory
Consectetur adipiscing elit.
Inpatient care
Consectetur adipiscing elit.
Surgical suite
Consectetur adipiscing elit.
Childbirth services
Consectetur adipiscing elit.
Our team
of specialists
Dr. Dania Amir, a seasoned healthcare professional with cross-continental experience, and Dr. Amir Hashmi, a seasoned operations and business leader, together lead GerMedCA with a vision to globalize German medical excellence.
Hear from our clients
Nam libero tempore, cum soluta nobis est eligendi optio cumque nihil impedit quo minus id quod.
Rodney Roy
At vero eos et accusamus et iusto odio dignissimos ducimus qui blanditiis praesentium voluptatum deleniti atque corrupti quos dolores et quas.
Mariam Gibbons
Sed ut perspiciatis unde omnis iste natus ut perspic iatis unde omnis iste perspiciatis ut rspiciatis.
Mark Burch
Excepteur sint occaecat cupidatat non proident, sunt in culpa qui officia deserunt mollit anim id est laborum. Nemo enim ipsam voluptatem quia.
Milan Coleman
Lorem ipsum dolor sit amet, consectetur adipiscing elit, sed do eiusmod tempor incididunt ut labore.
Russell Knight
Sed ut perspiciatis unde omnis iste natus ut perspic iatis unde omnis iste perspiciatis ut rspiciatis perspiciatis unde omnis iste natus ut perspic.

